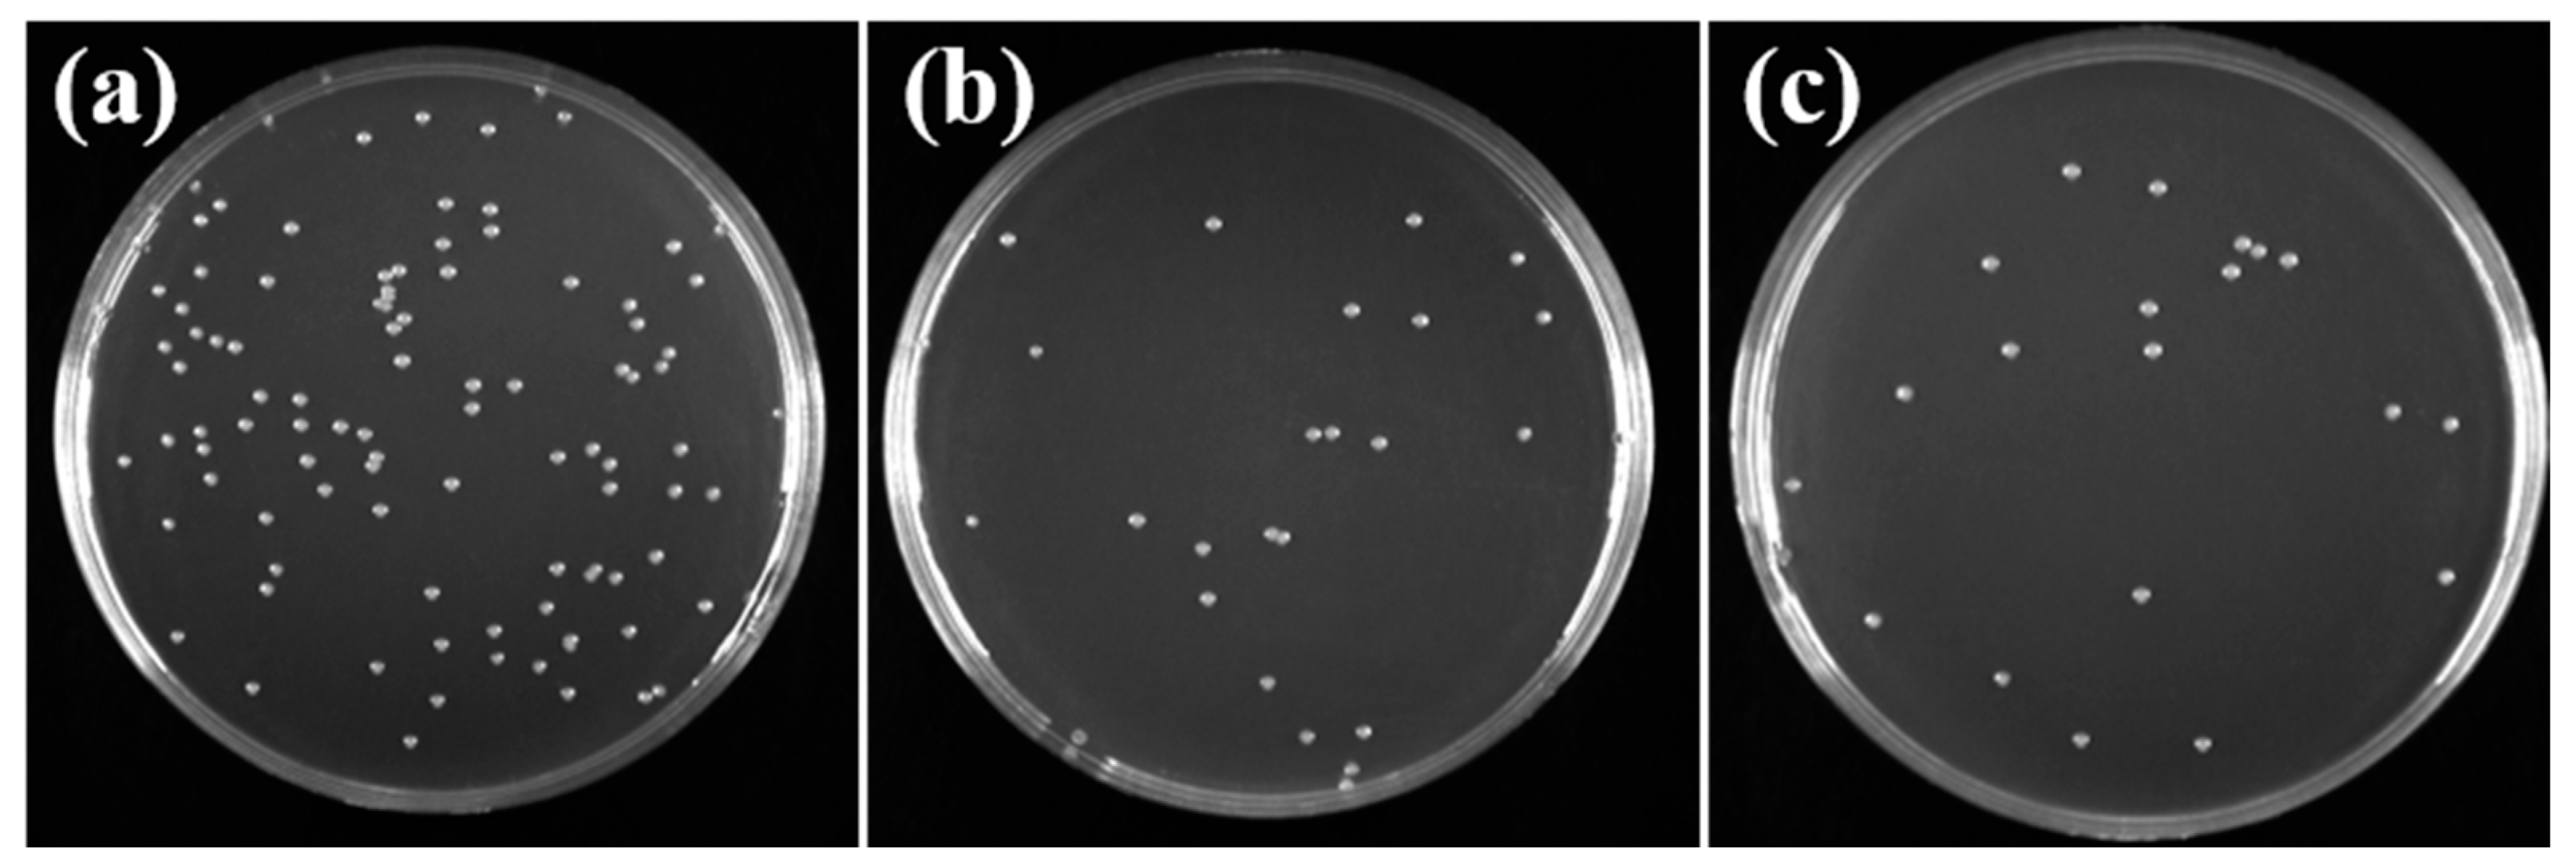
Molecules 30 00781 g012

Preparation of Highly Antibacterial Polyethersulfone/Sulfonated Polyethersulfone Blend Composite Membrane and Research on Its Dye Separation Performance
Abstract
:1. Introduction
2. Results and Discussion
2.1. Calculation of Blend Membrane Compatibility
2.2. Chemical Structure Analysis of PES/SPES Blend Membrane
2.3. Acidity and Viscosity Analysis of PES/SPES Blend Membrane
2.4. Morphological Characterization of PES/SPES Blend Membrane
2.5. Characterization of Physical Properties of PES/SPES Blend Membrane
2.6. Pore Size Test and Calculation of PES/SPES Blend Membrane
2.7. Separation Performance of Blend Membrane
3. Experiment
3.1. Experiment Materials
3.2. Preparation of Composite Membrane
3.3. Physical and Chemical Performance Characterization of Composite Membranes
3.3.1. Fourier Transform Infrared Spectroscopy (FTIR) and X-Ray Photoelectron Spectroscopy (XPS) Test
3.3.2. Viscosity Test
3.3.3. Porosity Test
3.3.4. Contact Angle Test Characterization
3.3.5. SEM Characterization
3.3.6. Atomic Force Microscopy (AFM) Characterization
3.3.7. Mechanical Performance Characterization
3.3.8. Molecular Weight Cut-Off (MWCO) Test
3.4. Separation Performance Test of Composite Membranes
3.4.1. Permeability Test
3.4.2. Dye Retention Rate
3.4.3. Antibacterial Experiment
4. Conclusions
Author Contributions
Funding
Data Availability Statement
Conflicts of Interest
References
- Chu, W. Dye removal from textile dye wastewater using recycled alum sludge. Water Res. 2001, 35, 3147–3152. [Google Scholar] [CrossRef] [PubMed]
- Shen, Z.; Yang, J.; Hu, X.; Lei, Y.; Ji, X.; Jia, J.; Wang, W. Dual electrodes oxidation of dye wastewater with gas diffusion cathode. Environ. Sci. Technol. 2005, 39, 1819–1826. [Google Scholar] [CrossRef] [PubMed]
- Nthunya, L.N.; Chong, K.C.; Lai, S.O.; Lau, W.J.; López-Maldonado, E.A.; Camacho, L.M.; Shirazi, M.M.A.; Ali, A.; Mamba, B.B.; Osial, M.; et al. Progress in membrane distillation processes for dye wastewater treatment: A review. Chemosphere 2024, 360, 142347. [Google Scholar] [CrossRef]
- Geise, G.M.; Lee, H.; Miller, D.J.; Freeman, B.D.; McGrath, J.E.; Paul, D.R. Water purification by membranes: The role of polymer science. J. Polym. Sci. Part B Polym. Phys. 2010, 48, 1685–1718. [Google Scholar] [CrossRef]
- Logan, B.E.; Elimelech, M. Membrane-based processes for sustainable power generation using water. Nature 2012, 488, 313–319. [Google Scholar] [CrossRef] [PubMed]
- Gu, S.; Ma, Y.; Zhang, T.; Yang, Y.; Xu, Y.; Li, J. MXene nanosheet tailored bioinspired modification of a nanofiltration membrane for dye/salt separation. ACS ES&T Water 2022, 3, 1756–1766. [Google Scholar]
- Jia, L.; Xu, X.; Zhang, H.; Xu, J. Permeation of nitrogen and water vapor through sulfonated polyetherethersulfone membrane. J. Polym. Sci. Part B: Polym. Phys. 1997, 35, 2133–2140. [Google Scholar] [CrossRef]
- King, S.; Escobar, I.; Xu, X. Ion beam irradiation modifications of a commercial polyether sulfone water-treatment membrane. Environ. Chem. 2004, 1, 55–59. [Google Scholar] [CrossRef]
- Razmjou, A.; Mansouri, J.; Chen, V. The effects of mechanical and chemical modification of TiO2 nanoparticles on the surface chemistry, structure and fouling performance of PES ultrafiltration membranes. J. Membr. Sci. 2011, 378, 73–84. [Google Scholar] [CrossRef]
- Miller, D.J.; Dreyer, D.R.; Bielawski, C.W.; Paul, D.R.; Freeman, B.D. Surface modification of water purification membranes. Angew. Chem. Int. Ed. 2017, 56, 4662–4711. [Google Scholar] [CrossRef]
- Rana, S.; Nazar, U.; Ali, J.; Ali, Q.U.A.; Ahmad, N.M.; Sarwar, F.; Waseem, H.; Jamil, S.U.U. Improved antifouling potential of polyether sulfone polymeric membrane containing silver nanoparticles: Self-cleaning membranes. Environ. Technol. 2018, 39, 1413–1421. [Google Scholar] [CrossRef]
- Rahimpour, A.; Jahanshahi, M.; Rajaeian, B.; Rahimnejad, M. TiO2 entrapped nano-composite PVDF/SPES membranes: Preparation, characterization, antifouling and antibacterial properties. Desalination 2011, 278, 343–353. [Google Scholar] [CrossRef]
- He, T.; Mulder, M.; Strathmann, H.; Wessling, M. Preparation of composite hollow fiber membranes: Co-extrusion of hydrophilic coatings onto porous hydrophobic support structures. J. Membr. Sci. 2002, 207, 143–156. [Google Scholar] [CrossRef]
- Rahimpour, A.; Madaeni, S.S.; Ghorbani, S.; Shockravi, A.; Mansourpanah, Y. The influence of sulfonated polyethersulfone (SPES) on surface nano-morphology and performance of polyethersulfone (PES) membrane. Appl. Surf. Sci. 2010, 256, 1825–1831. [Google Scholar] [CrossRef]
- Liu, X.; Hu, M.; Tao, R.; Cui, Z.; Ma, X.; Li, J. Preparation of Polyether Sulfone/Sulfonated Polyphenylsulfone/Sulfonated Polyether Sulfone Blend Porous Nanofiltration Membrane and Its Dye/Salt Selective Separation Performance. Membr. Sci. Technol. 2021, 4, 65–72. [Google Scholar]
- Zhao, J.; Wang, J.; Zhang, Y. Study on the Properties of a New Polyether Sulfone-Sulfonated Polyether Sulfone Blend Membrane. Water Treat. Technol. 2019, 45, 38–42. [Google Scholar]
- Klaysom, C.; Ladewig, B.P.; Lu, G.M.; Wang, L. Preparation and characterization of sulfonated polyethersulfone for cation-exchange membranes. J. Membr. Sci. 2011, 368, 48–53. [Google Scholar] [CrossRef]
- Tang, M.; Xue, J.; Yan, K.; Xiang, T.; Sun, S.; Zhao, C. Heparin-like surface modification of polyethersulfone membrane and its biocompatibility. J. Colloid Interface Sci. 2012, 386, 428–440. [Google Scholar] [CrossRef] [PubMed]
- Fang, L.F.; Yang, H.Y.; Cheng, L.; Kato, N.; Jeon, S.; Takagi, R.; Matsuyama, H. Effect of molecular weight of sulfonated poly (ether sulfone) (SPES) on the mechanical strength and antifouling properties of poly (ether sulfone)/SPES blend membranes. Ind. Eng. Chem. Res. 2017, 56, 11302–11311. [Google Scholar] [CrossRef]
- Guan, R.; Dai, H.; Li, C.; Liu, J.; Xu, J. Effect of casting solvent on the morphology and performance of sulfonated polyethersulfone membranes. J. Membr. Sci. 2006, 277, 148–156. [Google Scholar] [CrossRef]
- Sun, Z.; Zhao, G.; Chen, F.; Wang, A. Preparation and Characterization of Cellulose Acetate/Polyether Sulfone Blend Membranes in N,N-Dimethylacetamide/Lithium Chloride System. Membr. Sci. Technol. 2017, 37, 46–52. [Google Scholar]
- Yoo, S.H.; Kim, J.H.; Jho, J.Y.; Won, J.; Kang, Y.S. Influence of the addition of PVP on the morphology of asymmetric polyimide phase inversion membranes: Effect of PVP molecular weight. J. Membr. Sci. 2004, 236, 203–207. [Google Scholar] [CrossRef]
- Jung, B.; Yoon, J.K.; Kim, B.; Rhee, H.-W. Effect of molecular weight of polymeric additives on formation, permeation properties and hypochlorite treatment of asymmetric polyacrylonitrile membranes. J. Membr. Sci. 2004, 243, 45–57. [Google Scholar] [CrossRef]
- Rahimpour, A.; Madaeni, S.S. Improvement of performance and surface properties of nano-porous polyethersulfone (PES) membrane using hydrophilic monomers as additives in the casting solution. J. Membr. Sci. 2010, 360, 371–379. [Google Scholar] [CrossRef]
- Chakrabarty, B.; Ghoshal, A.; Purkait, M. Preparation, characterization and performance studies of polysulfone membranes using PVP as an additive. J. Membr. Sci. 2008, 315, 36–47. [Google Scholar] [CrossRef]
- Fang, L.F.; Jeon, S.; Kakihana, Y.; Kakehi, J.I.; Zhu, B.K.; Matsuyama, H.; Zhao, S. Improved antifouling properties of polyvinyl chloride blend membranes by novel phosphate based-zwitterionic polymer additive. J. Membr. Sci. 2017, 528, 326–335. [Google Scholar] [CrossRef]
- Meng, N.; Wang, Z.; Low, Z.-X.; Zhang, Y.; Wang, H.; Zhang, X. Impact of trace graphene oxide in coagulation bath on morphology and performance of polysulfone ultrafiltration membrane. Sep. Purif. Technol. 2015, 147, 364–371. [Google Scholar] [CrossRef]
- Meng, N.; Zhao, W.; Shamsaei, E.; Wang, G.; Zeng, X.; Lin, X.; Xu, T.; Wang, H.; Zhang, X. A low-pressure GO nanofiltration membrane crosslinked via ethylenediamine. J. Membr. Sci. 2018, 548, 363–371. [Google Scholar] [CrossRef]
- GB13022-1991; Plastics-Determination of Tensile Properties of Films. CSBTS (State Bureau of Technical Supervision): Beijing, China, 1991.
- Meng, N.; Sun, X.; Liu, J.; Mi, J.; Chen, X.; Rong, R. Modulation of Interlayer Nanochannels via the Moderate Heat Treatment of Graphene Oxide Membranes. Polymers 2024, 16, 2200. [Google Scholar] [CrossRef] [PubMed]
- GB4789.2-2016; National Food Safety Standard-Microbiological Examination of Food: Aerobic Plate Count. China Food and Drug Administration: Beijing, China, 2016.

| Polymer | Density /(g·cm2) | Unit Molar Mass M/(g·mol) | Solubility Parameter /(J1/2/mol1/2) |
|---|---|---|---|
| PES | 1.37 | 232 | 11.0 |
| SPES | 1.25 | 256 | 11.6 |
| Number | Polymer Content % | PES/g | SPES/g | PVP/g | DMAc/g |
|---|---|---|---|---|---|
| M20 | 20 | 1.92 | 1.28 | 0.8 | 16 |
| M22.5 | 22.5 | 2.22 | 1.48 | 0.8 | 15.5 |
| M25 | 25 | 2.52 | 1.68 | 0.8 | 15 |
| M27.5 | 27.5 | 2.82 | 1.88 | 0.8 | 14.5 |
| M30 | 30 | 3.12 | 2.08 | 0.8 | 14 |
Disclaimer/Publisher’s Note: The statements, opinions and data contained in all publications are solely those of the individual author(s) and contributor(s) and not of MDPI and/or the editor(s). MDPI and/or the editor(s) disclaim responsibility for any injury to people or property resulting from any ideas, methods, instructions or products referred to in the content. |
© 2025 by the authors. Licensee MDPI, Basel, Switzerland. This article is an open access article distributed under the terms and conditions of the Creative Commons Attribution (CC BY) license (https://creativecommons.org/licenses/by/4.0/).
Share and Cite
Meng, N.; Mi, J.; Chen, X.; Liu, J.; Zhu, H.; Zheng, X. Preparation of Highly Antibacterial Polyethersulfone/Sulfonated Polyethersulfone Blend Composite Membrane and Research on Its Dye Separation Performance. Molecules 2025, 30, 781. https://doi.org/10.3390/molecules30040781
Meng N, Mi J, Chen X, Liu J, Zhu H, Zheng X. Preparation of Highly Antibacterial Polyethersulfone/Sulfonated Polyethersulfone Blend Composite Membrane and Research on Its Dye Separation Performance. Molecules. 2025; 30(4):781. https://doi.org/10.3390/molecules30040781
Chicago/Turabian StyleMeng, Na, Jialing Mi, Xuan Chen, Jinxin Liu, Hualei Zhu, and Xiaoyu Zheng. 2025. "Preparation of Highly Antibacterial Polyethersulfone/Sulfonated Polyethersulfone Blend Composite Membrane and Research on Its Dye Separation Performance" Molecules 30, no. 4: 781. https://doi.org/10.3390/molecules30040781
APA StyleMeng, N., Mi, J., Chen, X., Liu, J., Zhu, H., & Zheng, X. (2025). Preparation of Highly Antibacterial Polyethersulfone/Sulfonated Polyethersulfone Blend Composite Membrane and Research on Its Dye Separation Performance. Molecules, 30(4), 781. https://doi.org/10.3390/molecules30040781






